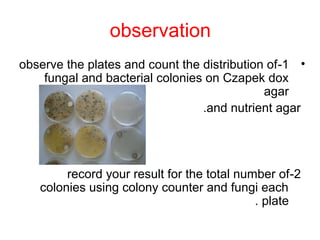
observation
•1-observe the plates and count the distribution of
fungal and bacterial colonies on Czapek dox
agar
and nutrient agar.
2-record your result for the total number of
colonies using colony counter and fungi each
plate.

Microorganisms are commonly found suspended in air, including bacteria, fungi, algae, viruses, and protozoa. The most important factors affecting the types and numbers of airborne microorganisms are temperature, humidity, and air currents. While air is not suitable for microbial growth, it acts as a transport medium for microbes picked up from environmental sources like soil, water, and human activities like coughing and sneezing. Methods to isolate microorganisms from air samples include impingement onto solid or into liquid collection media, followed by incubation and counting of colonies.